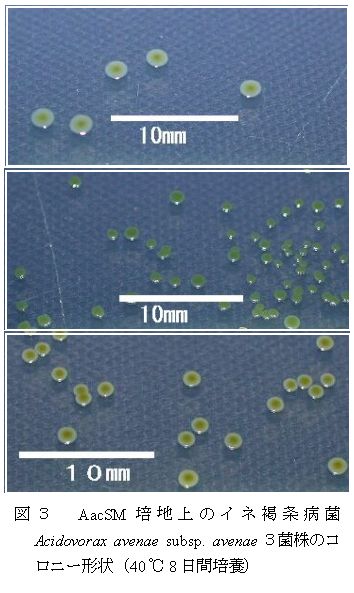

イネ種子からのもみ枯細菌病菌及び褐条病菌の効率的な生菌回収法 |
||||||||
| [要約] | ||||||||
イネ種子100gを250ml水中で超音波処理し、メンブレンフィルター法で集菌し、再度フィルターを10ml水中に浸漬して超音波処理を行う。この処理液をもみ枯細菌病菌及び褐条病菌の選択培地で培養することで、比較的大量の種子から両病原細菌の検出及び分離が可能となる。 |
||||||||
[キーワード]イネもみ枯細菌病、イネ褐条病、種子、メンブレンフィルター法、選択培地 |
||||||||
[担当]千葉農総研・生産環境部・病理研究室 [連絡先]電話043-291-9991 [区分]関東東海北陸農業・関東東海・病害虫(病害) [分類]科学・参考 |
||||||||
| [背景・ねらい] | ||||||||
イネの育苗期に発生する種子伝染性細菌病が問題となっている。また、もみ枯細菌病や褐条病では薬剤耐性菌の発生が確認されている。種子の汚染状況や耐性菌の有無を把握することは、優良種子の生産及び安定供給を図り、適切な防除指導を行っていく上できわめて重要である。特に薬剤耐性を検定するためには生菌を回収することが必要である。そこで、保菌率が低いと考えられる流通種子から、メンブレンフィルター法を改良したイネもみ枯細菌病菌と褐条病菌の同時検出を試みる。 |
||||||||
[成果の内容・特徴] |
||||||||
|
||||||||
[成果の活用面・留意点] |
||||||||
|
||||||||
|
||||||||
|
||||||||
[その他] |
||||||||
研究課題名:イネ苗立枯性細菌病薬剤耐性菌の発生と防除 |
||||||||
| 目次へ戻る |